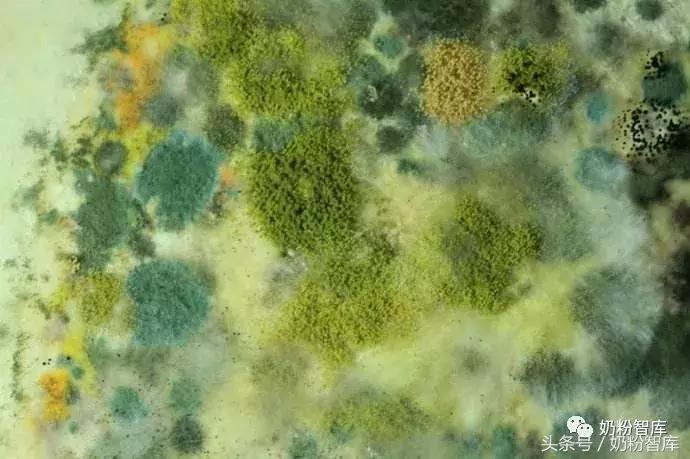
澳洲奶粉受污染事件,国外疫情严重进口奶粉能放心买吗

粉哥导读:近年来国外的奶粉总是风波不断,而本月特别多。才刚进入下旬,就已经发生好几起奶粉“污染”事件,这是给“多事之秋”应景来了么?一会儿检出沙门氏菌,一会儿阪崎肠杆菌污染,一会儿又是霉菌和金黄色葡萄球菌超标了,弄得是人心惶惶。
作者:想想妈(高级营养师)
投稿:2216295723@qq.com

7月27日,欧盟食品和饲料类快速预警系统(RASFF)通报爱尔兰疑似受污染的婴幼儿奶粉已经出口到德国、法国、挪威和波兰。8月17日,爱尔兰农业、食品和海事部发布公告称:根据调查结果显示,没有证据证明上述法国婴儿沙门氏菌病例与爱尔兰产婴幼儿配方奶粉有任何因果关系。竟是虚惊一场!
制造这一“乌龙门”的正是半年前深陷沙门氏菌污染的法国,预警处理及时值得赞赏,只是爱尔兰无辜躺枪,也着实委屈。就在爱尔兰奶粉污染“乌龙门"落幕当天,欧盟RASFF又发警示。本月奶粉污染事件真是“扎堆”来。
1
7月27日-8月10日
智利卫生部连续检测出雀巢NAN早产儿奶粉受污染批次:
7月27日,智利卫生部发布一则食品安全预警称,批号为L80190346AH的雀巢NAN早产儿配方奶粉检测出霉菌超标。
8月8日,检测出批号为L80480346AT的产品也存在霉菌超标的情况;
8月10日,批号为L72080346AB的幼儿奶粉检测出金黄色葡萄球菌超标。
早产儿一般发育不完善,免疫力较足月儿更差,致病菌对其危害更大。这些批次均在其国内销售,并未流入中国。
2
8月17日
即爱尔兰沙门氏菌“乌龙门”事件澄清之日,欧盟再发三则警示:

荷兰通过RASFF发出两则警示:荷兰产婴幼儿配方奶粉分别被发现真菌污染与金黄色葡萄球菌污染,由荷兰自检发现,欧盟将其风险标注为“严重”。该奶粉除了荷兰本土销售外,还被出口至智利与玻利维亚等国,被污染奶粉要求召回并“销毁”。
斯洛文尼亚通过RASFF发布信息:8月7日,由爱尔兰生产经由荷兰进口的婴幼儿配方奶粉发现死昆虫。这是由消费者投诉发现,风险标注未标识“严重”。而该奶粉被出口至斯洛文尼亚、匈牙利及克罗地亚。
3
8月20日
新加坡农业食品兽医管理局发布“Recall of Dumex Mamil Gold Infant Milk Formula -Step 1 (850g)”的公告:多美滋Mamil Gold婴儿配方奶粉 -Step 1(850克)的样本中检测到阪崎肠杆菌,并已指示进口商Danone Dumex召回受影响的产品。

以上受污染奶粉并未波涉及中国市场,但不能排除已经随海淘或代购渠道进入中国,特别提醒正在给宝宝吃海淘奶粉的爸妈们需留意。
国外尤其是欧盟标准的奶粉,被人们认为是安全度比较高的。可是近年来这些接二连三的奶粉致病菌污染事件,也体现出了国外某些乳企在奶粉生产环境上管控的严苛度不够,令人担忧。
致病菌对宝宝危害有多大?
1、沙门氏菌

沙门氏菌是一种属于肠杆菌科的革兰氏阴性杆菌,是腹泻病全球病因之一,主要传播源为食用动物,如禽类、猪和牛,耐受温度72℃。每年全球因感染沙门氏菌而死亡的人数达10万人以上。沙门氏菌对青壮年而言一般症状轻微,但是对免疫力较弱的宝宝和老人威胁较大,严重时可引发败血症甚至危及生命,据世界卫生组WHO的资料显示,全球每年有5.5亿人患病,其中2.2亿名为五岁以下儿童。
沙门氏菌致病剂量很低,FAO/WHO将沙门氏菌属归属A类病原微生物,国际上对婴幼儿配方奶粉中沙门氏菌都有严格的限量标准。我国2010年颁布实施的《食品安全国家标准 婴儿配方食品》(GB 10765)和《食品安全国家标准 较大婴儿和幼儿配方食品》(GB 10767)对沙门氏菌有严格的限量标准,即1、2、3段中沙门氏菌的检出值均为0。
2、阪崎肠杆菌

即克罗诺杆菌,是人和动物的肠道致病菌,致病剂量较低,耐受温度72℃。人与人之间无传染性,奶粉是阪崎肠杆菌的主要感染源。所以婴幼儿是该类致病菌的高危人群,尤其新生儿、早产儿和低体重儿致病最高,轻症愈后良好,重症可引起坏死性小肠结肠炎、败血症、脑膜炎等且致死率高。
国际食品法典委员会(CAC)、欧盟委员会(EC)、美国食品药品管理局(FDA)及中国国家标准要求,在6个月以下的婴儿配方奶粉中不得检出阪崎肠杆菌。
3、金黄色葡萄球菌

金黄色葡萄球菌广泛存在于自然环境中,是细菌性食物中毒的主要致病菌之一,营养需求低,在干燥环境下可存活数天,适宜繁殖温度为37℃,夏秋为流行季。被污染食物易引起呕吐、腹泻、脱水,严重可引起中毒性休克。
由于其耐高温性差,存在广泛,重症威胁相对较低,各国在婴幼儿奶粉中限量标准,一般是允许限量存在,检出量不得超出规定的安全限量临界值。
4、霉菌
霉菌是一类真菌,寄生或腐生方式生存,分布广泛,喜潮湿环境。霉菌使食物变质后产生的霉菌毒素,对人体健康危害极大,除了引起食物中毒外,还具有致癌、致畸等作用,如果长期摄入含有霉菌的食物,对宝宝远期健康影响严重。在奶粉中有严格的安全限量要求,不得超标。
如何避免宝宝感染致病菌?
1、企业食品安全应高于一切
首先呼吁奶粉制造商严把奶粉质量关,无论是奶源、配料,还是生产车间方面,应严格监管每一个安全控制关键点,做到防微杜渐,需具有将宝宝食品质量安全放在首位的企业良心和社会责任感。
2、选择正规渠道购买奶粉,海淘需谨慎
尽量在正规母婴店、商超渠道购买,谨慎选择海淘代购。选择进口奶粉时,请认准中文包装,中文包装奶粉入关会批批抽检,无论是产品安全及营养上都会严格监控,只有符合食品安全要求的奶粉才能入关销售。而通过海淘代购的奶粉,由于渠道混乱,导致监管难度大,很可能买到上述受污染奶粉。
其实,这一年多以来,国外大大小小的奶粉污染事件,基本未波及我国奶粉市场。也与这些年来,我国采取的一系列安全监管措施有关,如进口奶粉生产商注册备案、婴幼儿配方乳粉产品配方注册,通过日常抽查、月月抽检、飞行检查、体系检查等诸多方式对国产及进口奶粉进行严格的食品安全监控。
3、注意宝宝饮食卫生
上述奶粉污染事件中涉及的这些致病菌,除了沙门氏菌和阪崎肠杆菌主要由奶粉感染外,其他致病菌在日常环境中也广泛存在,注意宝宝饮食卫生也极为重要。
宝宝的奶瓶、玩具等宝宝常接触的东西需定期消毒;家人在冲调奶粉时,应先肥皂洗手,并注意穿着卫生。夏秋季节是致病菌较活跃的季节,爸妈们需尤其注意。
可以选择70℃的水冲调奶粉,这是避免感染沙门氏菌和阪崎肠杆菌比较有效的方法,不过这个水温会破坏少量维生素。目前奶粉质量安全监管严格,用40-50℃的水温是可以放心的。